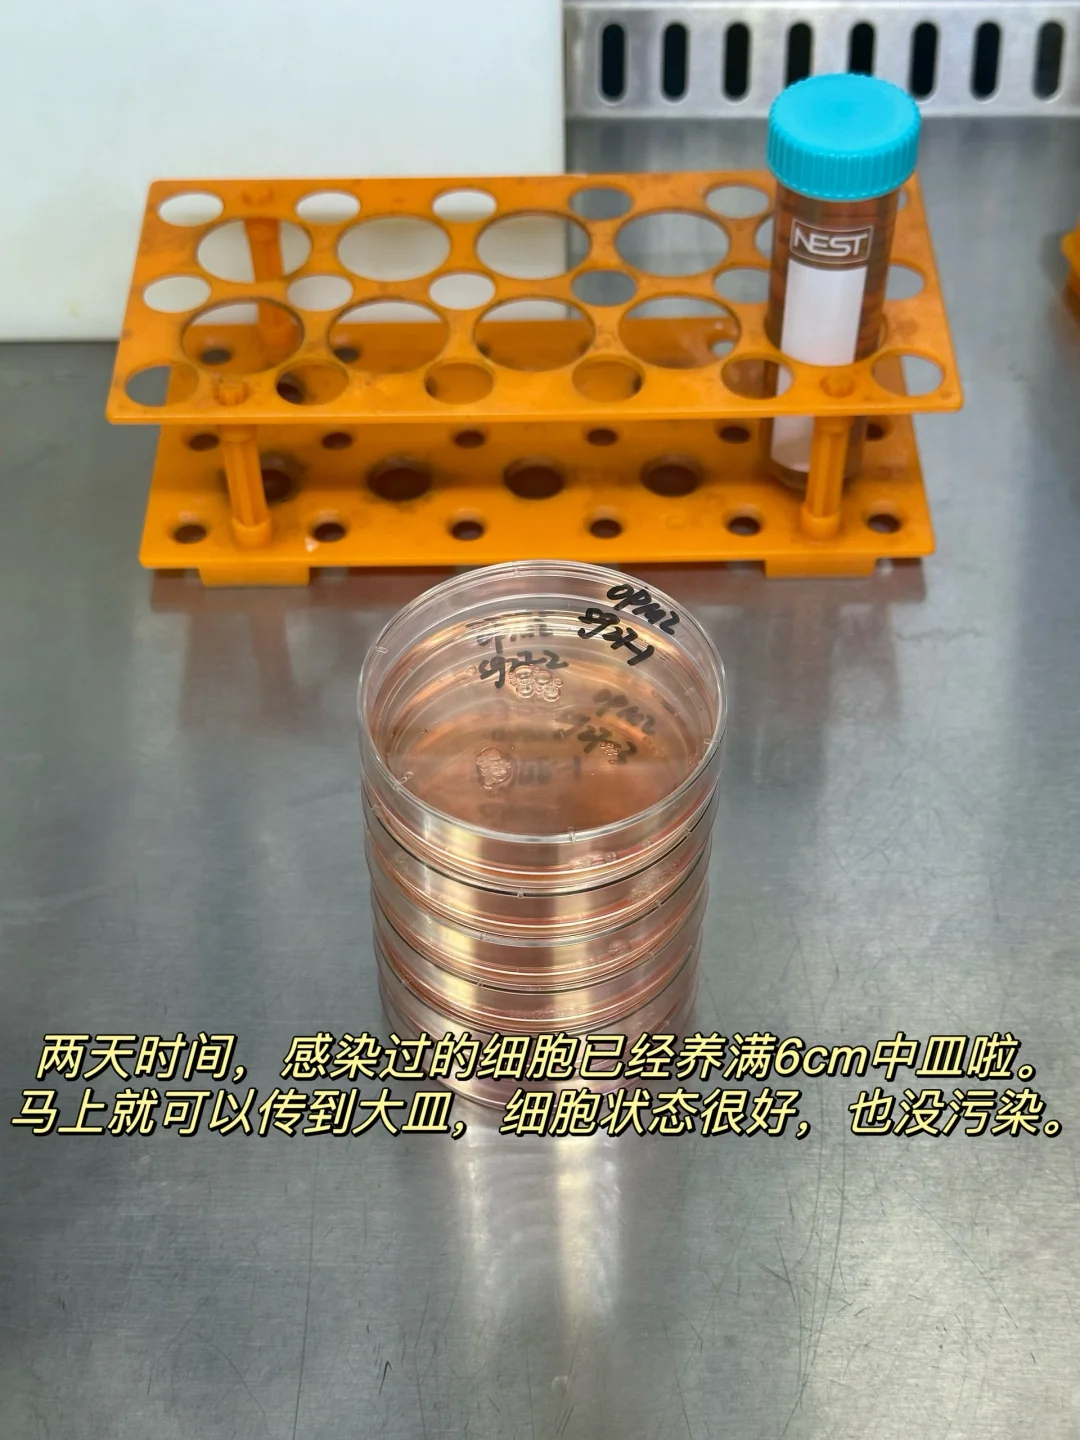

老有宝子问我关于悬浮细胞慢病毒感染的问题,其实之前已经出过一些干货贴了,今天总结了一下分享给大家。
🫡这篇笔记包括慢病毒包装protocol和注意事项,慢病毒感染细胞tips,以及构建稳株和嘌呤霉素筛选tips。
(从包装病毒到收集病毒,筛选稳株整个流程的一套干货都给大家出了!码住![生气R])
👍超级无敌巨详细的文字版本在第7、8张图~
🧫除此之外:我这里测试了自配慢病毒浓缩液和商品化慢病毒浓缩液的使用效果比较。
1、自配的用的是PEG8000➕4M Nacl(之前发过配方)
缺点是:用量大,20ml病毒液就需要加大概10ml浓缩液去浓缩,浓缩效果不稳定,有时候很好有时候只能说还凑合。
2、商品化的是用的和元李记生物的慢病毒浓缩液(图上有说明)
优点:用量少,20ml原病毒液只需要用1/4的浓缩液去浓缩,离心之后的病毒沉淀比自配的多很多,并且感染效果也👍。
🧫用的同样的细胞,同样的质粒做的病毒,和元李记浓缩出来的病毒沉淀比自配的病毒浓缩液多挺多。
⚠️⚠️⚠️但用自配的浓缩液的话,大家根据我写的protocol和tips,感染效果也不会差。
🧫如果有条件的宝子还是建议买商品化的产品去浓缩病毒,如果课题组原因,也可以自配,我之前也都是自配的,效果也还可以,只不过比和元的逊色一些,大家根据自己情况选择。